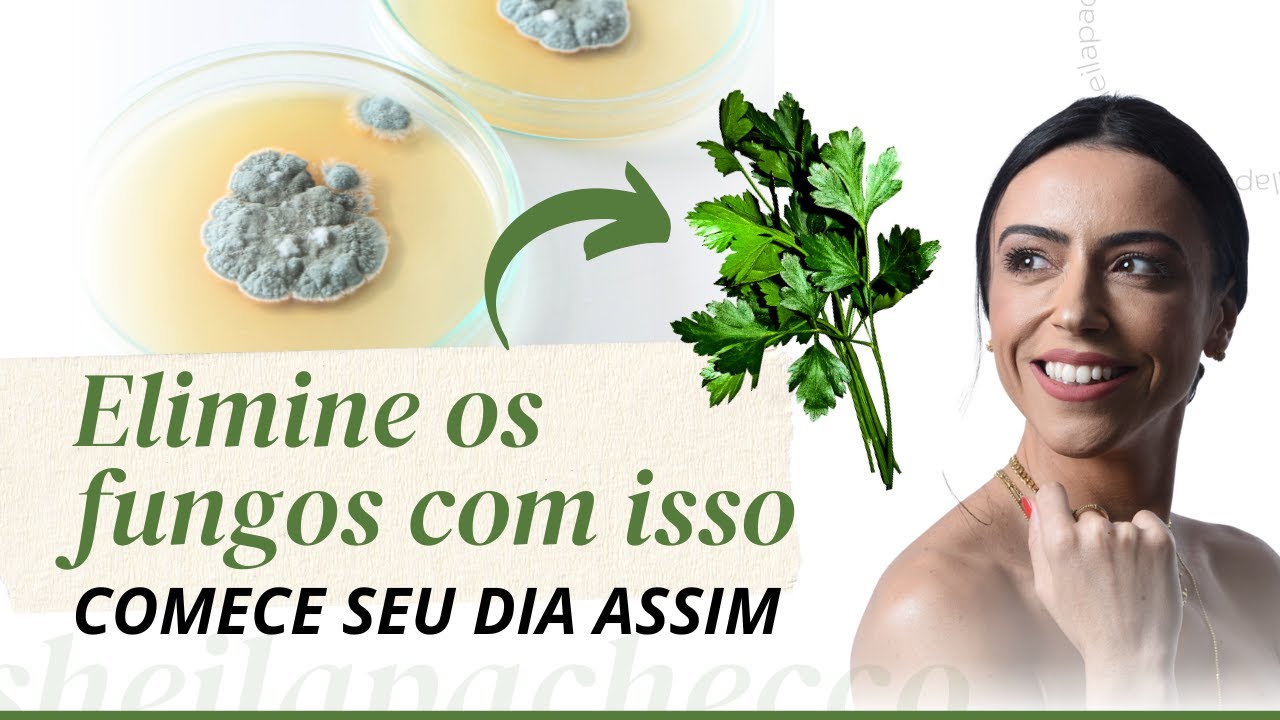
Café da Manhã Antifúngico | COMECE BEM O SEU DIA

nesse vídeo você vai saber como se livrar de uma vez por todas da sua candidíase vaginal através da sua dieta Esse é um dos principais pilares do tratamento se não for o principal Pilar fica até o final do vídeo porque eu vou te dar uma lista dos alimentos que você deve retirar e inserir no seu dia a dia seja muito bem-vindo ao meu canal meu nome é Taís amistaldi e a minha missão aqui é levar saúde para dentro da sua casa por isso neste canal falando sobre saúde como todo com foco muito especial em saúde
digestiva e saúde intestinal mas primeiro vamos entender rapidinho o conceito geral para você saber qual o motivo de retirar e de inserir certos alimentos na sua rotina alimentar como eu falei nesse vídeo aqui o motivo para sua candidíase vaginal que não vai embora apesar dos tratamentos medicamento que você já fez é porque os fungos estão concentrados aumento de quantidade no seu intestino enquanto a gente não tratar o seu intestino não melhorar toda a sua agora intestinal principalmente pensando no excesso de fungos que estão ali nós não teremos um tratamento adequado e uma real melhora da
sua candidíase vaginal entenda que mesmo que seja necessário o uso de alguma medicação antifúngica ou de fitoterápicos que também tem ação antifúngica se você não mudar o seu padrão alimentar nós não teremos uma eficácia nesse tratamento porque porque foi seu padrão alimentar um dos principais Pilares que te levou a desenvolver todos essa super proliferação fúngica tanto no seu intestino quanto na sua vagina portanto se a gente não tratar a base que é principal alimentar não adianta a gente tomar medicação não adianta a gente tomar os melhores fitoterápicos porque é melhor vai ser apenas momentânea depois
que retirarmos o uso das medicações ou dos fitoterápicos e mantermos os mesmos hábitos principalmente os hábitos alimentares anteriores esse super crescimento fúngico voltará ocorrer Além disso bom aporte nutricional vai auxiliar para que o seu sistema tecnológico tem a forças seja empoderada tem as armas necessárias para brecar essa super proliferação fúndica portanto a terapia nutricional é determinante para o bom tratamento da síndrome fúngica ou da candidíase vaginal de repetição um padrão alimentar adequado e saudável irá te ajudar principalmente em quatro fatores na melhora da sua microbiota intestinal de toda a flora que habita o seu intestino
na melhora da composição da parede intestinal que pelo excesso de fungos no intestino está machucada está hipermeável e isso aumenta essa translocação dos fungos que estão no intestino até outras mucosas como a vagina vai dar um aporte importantíssimo para o seu sistema imunológico ficar mais empoderado e mais eficiente vai auxiliar no detox do fígado o fígado é responsável por pegar várias toxinas que estão no nosso organismo transformá-las numa que ela seja excretada através das setas através da urina ou através do suor quando nós temos um super crescimento fúngico no intestino na vagina esses fungos Eles
produzem muitas toxinas então o nosso fígado fica sobrecarregado por ter que fazer muito detox uma boa dieta com bom aporte nutricional proteico de vitaminas de micronutrientes vai auxiliar em toda essa detoxicação antes da gente entrar na lista de alimentos tão esperado que você deve inserir ou retirar da sua alimentação para que você se livra de uma vez por toda dessa candidíase tenha mais saúde eu separei seis comportamentos básicos para você adquirir a partir de agora e é importante que você mude a sua mentalidade que você coloque isso na sua cabeça internaliza isso nos seus pensamentos
para que você consiga colocar esses fatores comportamentais em prática que vai ser super importante para que você realmente consiga um tratamento o primeiro deles é você ter a consciência de que tudo no seu organismo é feito de nutrientes tudo inclusive seu sistema imunológico para ele funcionar de forma adequada ele precisa de nutrientes e esses nutrientes vem de uma alimentação mais limpa ricas em alimentos de verdade alimentos que a gente retira da natureza então rica principalmente em frutas leguminosas verduras vegetais como um todo por isso eu vou para o segundo comportamento que é a preocupação de
que você deve ingerir alimentos mais naturais possíveis e o terceiro que vem acompanhado com o segundo é que você livre-se dos atos de consumir alimentos prontos alimentos empacotados industrializados que são recheados de produtos químicos péssimos para sua saúde o quarto é a preocupação do preparo do seu alimento quando preparamos um alimento em casa Nós realmente sabemos o que está contido ali dentro qual o óleo foi utilizado para fazer aquela refeição faz tempero se foram prontos cheios de corantes aromatizantes ou se foi temperos naturais tudo isso é super importante a longo prazo faz toda a diferença
na nossa saúde então se você consegue preparar os seus alimentos em casa é a melhor forma possível o quinto é dar importância para o momento da refeição isso é super importante para que você realmente seja presente naquela refeição e tenha uma boa digestibilidade e o sexto ficou por último mas é super importante é se alimentar em horários corretos isso tudo vai fazer com que junto com uma dieta adequada com os alimentos adequados melhore globalmente o seu estado de saúde então agora vamos a hora mais esperada que é quais alimentos você deve retirar e inserir no
seu dia a dia Vale lembrar que eu não gosto de nenhuma dieta muito restrita a nossa alimentação ela deve ser mais diversificado e a mais colorida possível então eu vou falar alguns alimentos devem ser retiradas Mas pense que é por um momento é Até você melhorar todo esse seu quadro clínico depois não são alimentos que é legal você ingerir todos os dias na sua dieta na sua rotina constantemente mas são alimentos que eventualmente podem estar inseridos na sua dieta então não pense que é uma dieta restritiva é apenas por esse momento Até você se livrar
de uma vez por todas dessa candidíase os alimentos que você deve retirar são principalmente dividido em dois grupos os alimentos que os fungos gostam de se alimentar ou seja quando você ingere esses alimentos eles entram em contato ali no intestino e os fungos que estão ali se alimentam desses alimentos então eles fermentam esses alimentos esses alimentos devem ser retirados para que a gente realmente tenha uma diminuição da quantidade de fungos tanto no seu intestino quanto na sua vagina e o segundo grupo são os alimentos que são contaminados por fungos que devem ser re porque se
você ingere os alimentos que tem fungo ali na composição dele se você tá colocando mais fungo para dentro do seu organismo mas fungo para o seu intestino e a gente não vai conseguir uma real melhor Vamos iniciar com a lista de alimentos que você deve retirar Que são fontes de fermentação para os fungos eles são principalmente todos os lacchos todos os açúcares todos os açúcares inclui açúcar de coco açúcar demerara todos os açúcares disponíveis mesmo que sejam mais saudáveis são alimentos riquíssimos para os fungos fermentar o cítricos e aqui entra a laranja o limão a
mexerica ponkan sucos de uva ou de maçã que são altamente fermentadas pelos fungos álcools e carboidratos refinados Quais são esses carboidratos refinados são aqueles que a gente tem menor quantidade de nutriente e menor quantidade de fibras Então são principalmente os farináceos e o principal deles é a farinha de trigo três alimentos quando chegam ali no intestino são altamente fermentadas pelos fungos e geram todos os desconsportos inclusive digestivos de gases de distensão abdominal arrotos constipação intestinal então todos esses vale a pena retirar pelo menos no período do tratamento o segundo grupo de alimentos que devem ser
retirados são os alimentos que são contaminados por fungos e aqui entra amendoim oleaginosas como nozes castanha do Pará castanha de caju amêndoas grãos como milho frutas secas como uva passa banana Damasco ameixa todas essas frutas são ricas em açúcares e também são contaminadas por fungos e vai fazer um estrago na sua microbiota intestinal Além disso o vinagre azeitona os produtos em conservas fermento biológico levedo de cerveja e os alimentos que estão na geladeira por mais de dois dias por mais que eles estejam bem conservadinhos ficou o tempo todo ali na geladeira Muito provavelmente tem alguma
contaminação de fungo que ele acabou se proliferando um pouco mais nesse tempo que ficou na geladeira Então nesse momento é importante que você consuma alimento do dia ou no máximo do dia anterior e sabe aquelas frutas que aquele mamão por exemplo que na no biquinho dele assim fica um pouquinho uma lesãozinha assim de fundo fica um pouquinho meio amarronzado até um pouquinho esbranquiçado assim que a gente sabe que tem um fungo ali normalmente que que a gente faz a gente corta aquela parte e joga lá fora e come o resto Pois é isso você não
vai poder fazer nesse momento porque aquela parte que tem fungo ali é a parte visível Mas isso não quer dizer que em outras partes daquele mamão também não tem um fundo Muito provavelmente tem só não tá visível ainda então se você tem uma síndrome fúngica é legal que você não consuma nada que possa ter algum nível de fundo esses alimentos que estejam assim é importante ficar de olho e não consumimos então é importante quanto retirar esses alimentos é inserir alimentos importantes para o tratamento da síndrome fúngica e aqui eu gosto de te dizer o seguinte
tem em mente que os melhores alimentos para você consumir diariamente na sua rotina são legumes frutas vegetais e proteínas pode ser ovos peixes carne de vaca carne de porco enfim a proteína que você prefira consumir exceto os alimentos que eu disse acima então se você pensar que todos os alimentos que vieram da natureza seja eles vegetais ou sejam eles de origem animais que não foi empacotado sabe que você tira da natureza você descasca cozinha e come É tipo isso sem pacotinho sem ficar um tempão ali na prateleira do supermercado todos eles são adequados para você
consumir exceto o que eu falei ali em cima porque tem essa peculiaridade ou de ser alimentos fermentados pelos fungos ou de serem contaminados só que vai uma lista dos alimentos muito interessantes para você colocar no seu dia a dia e eu vou começar pelo alho e pela cebola extremamente se forem Cruz eles são excelentes antifúngicos O alho quando a gente amassa ele até coloca numa tábua e a massa bastante com a ponta da faca assim ele libera um suquinho branquinho não sei se você já reparou esse suco branco é super importante tem ótimas propriedades antifúngicas
Então como alho que seja bastante amassadinho bastante vegetais nas formas cruas também são importantes porque eles possuem fibras E essas fibras vão ajudar em toda a modulação dos seus microrganismos intestinais aqui vai uma lista dos que eu mais que são alfafa repolho chicória aipo abobrinha cenoura nabo agrião alface acelga todos esses vão te dar uma boa quantidade de fibras e vai ajudar até na sua evacuação caso você tenha constipação as leguminosas também são muito importantes como lentilha feijão e ervilhas mas é importante deixar elas de antes de cozinhar Eu gosto de fazer um remolho que
que é isso Você deixa em Água de molho fora da geladeira por 12 a 24 horas e vai trocando a água nesse período porque você vai perceber que em cima da água vai ter uma espuminha branca essa espuminha forma muitos gases e tem fitatos que é um anti nutriente ele prejudica a absorção de alguns nutrientes no seu intestino principalmente de Ferro então é importante que a gente tira toda essa espuminha Branca por isso deixar de molho quando levantar espuminha tira essa água lava deixa de molho mais uma vez vai levantar mais espuminha você tira coloca
água de novo e vai fazendo isso até que a água fique totalmente limpa e isso demora um pouco até essa espuminha formar vai demorar algumas horas então por isso de 12 a 24 horas de molho além disso a semente de linhaça é muito legal você pode colocar em shakes ou você pode colocar em cima da salada óleo de coco também é super importante o óleo de coco ele é um antifúngico super interessante super importante então você pode usar o óleo de coco no preparo de todos os seus alimentos inclusive dos legumes ou você pode colocar
um pouquinho no café por exemplo uma colherzinha de óleo de coco no Café mistura bem ou até mesmo regar salada com um pouquinho de óleo de coco quase você gosta mais do sabor dele óleo de orégano também é fundamental e ele é super gostoso para temperar salada então dá para você comprar um óleo de orégano de boa qualidade de boa procedência e utilizar todo dia no tempero da sua salada algum chá também são muito interessantes como chá verde o chá de camomila e o chá de alecrim e claro usar muitas especiarias ervas temperos naturais na
sua cozinha sorvete orégano que é um excelente antifúndico o alecrim cravo tomilho hortelã e o óleo de coco como eu já havia dito Espero que você tenha pegado papel e caneta Se não fez isso volta o vídeo veja de novo toda essa lista vai anotando Quais alimentos você deve retirar e inserir porque vai fazer Total diferença no seu tratamento contra candidíase de repetição e também na sua liberdade né Ninguém merece ficar vivendo com essa Cândida aí Espero que você tenha gostado do vídeo aqui tenha sido de muita valia para você manda esse vídeo para alguma
amiga para sua mãe para algum parente que você sabe que sofre com essa maldita Cândida se inscreve no canal ativa o Sininho dá o seu like para que a gente consiga alcançar mais e mais pessoas e levar saúde para casa demais pessoas e fique por aqui que toda semana tem vídeos incríveis para você [Música]